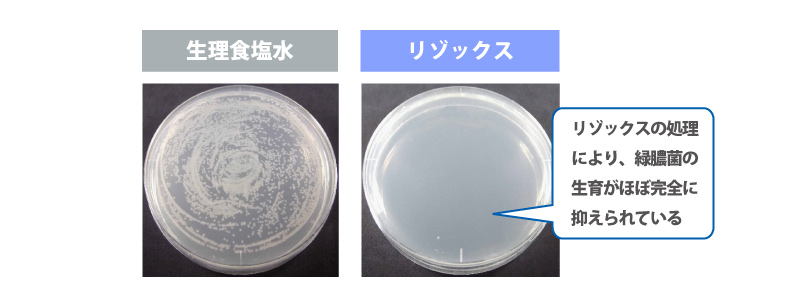
生理食塩水　リゾックス　リゾックスの処理により、緑膿菌の生育がほぼ完全に抑えられている
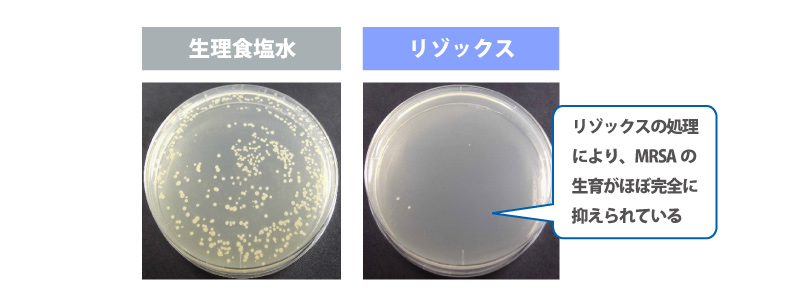
生理食塩水　リゾックス　リゾックスの処理により、MRSAの生育がほぼ完全に抑えられている

-
グラム陽性菌に対する溶菌作用(抗菌機能)
グラム陽性菌(注1)に対するリゾックスの作用を可視化するために、生きた菌の濃縮液にリゾックスを添加し、液の状態を観察した。 菌により白濁した液は、リゾックスの添加により菌が分解されてしまい(これを溶菌と呼ぶ)、白濁の液が透明になったことが判る。



リゾックスは菌に対して溶菌効果を示す
(注1)グラム陽性菌とは…
グラム染色により紺青色あるいは紫色に染色される細菌の総称。外膜を持たず、厚いペプチドグリカン層がある事が特徴。
(「グラム陽性菌」『フリー百科事典 ウィキペディア日本語版』(http://ja.wikipedia.org/)更新日付: 2019年8月6日0時(UTC)現在での最新版より抜粋して引用。))
手の常在菌に対する効果試験(抗菌機能)
手をはじめヒトの身体の内外には、常在菌と呼ばれる多くの雑菌が存在している。 菌を増殖させ可視化させる培地に手のひらを押し当てると、手のひらに存在していた菌が集合体として見る事ができる(写真左)。一方、リゾックスを添加した培地では菌の増殖が見られない。(写真右)



リゾックスは手の皮膚表面の雑菌(常在菌)
の増殖を抑える
メチシリン耐性黄色ブドウ球菌(注1)(通称:MRSA)への抗菌効果
黄色ブドウ球菌は健康な人の身体にいる常在菌の1つで、体力の低下などで免疫力が弱ると日和見感染症(注2)を引き起こす。MRSAは抗生物質のメチシリンに耐性を持つ(効きにくい、効かない)黄色ブドウ球菌という意味であるが、実際の世の中ではメチシリン以外の多種類の抗生物質薬剤に耐性を持つ「多剤耐性菌」の呼称である。免疫力の低い人の多い病院内や介護施設内で集団感染を引き起こすことで知られている。リゾックスはこのMRSAに対して抗菌性を示す事が東京医科歯科大学呼吸器内科との共同研究で判明し、同大学にて公式発表がなされた。

東京医科歯科大学呼吸器内科 共同研究
東京医科歯科大学呼吸器内科 共同研究
PLoS ONE. 2019 May 28, 14(5): e0217504リゾックスはMRSAに対して抗菌効果を示す
(注1)メチシリン耐性黄色ブドウ球菌(MRSA)とは
抗生物質メチシリンに対する薬剤耐性を獲得した黄色ブドウ球菌の意味。 本菌が免疫力が低下した患者に感染すると、通常では本菌が起こすことはないような日和見感染を起こす。一旦発症するとほとんどの抗生物質が効かないため、治療は困難である。特に、術後の創部感染、骨感染(骨髄炎・関節炎)、感染性心内膜炎(IE)、臓器膿瘍は難治性化し、適切な治療を受けられないと、後遺症ばかりか死の転帰をたどることになる。
(「メチシリン耐性黄色ブドウ球菌」『フリー百科事典 ウィキペディア日本語版』 http://ja.wikipedia.org/) 更新日付:2020年4月2日13:24(UTC)現在での最新版より抜粋して引用。)(注2)日和見感染症とは
健康な動物では感染症を起こさない病原体(弱毒微生物・非病原微生物・平素無害菌などと呼ばれる)が原因で、発症する感染症である。 日和見感染を起こす病原体の中には薬剤耐性を獲得しているものも含まれており、いったん発病した場合にその治療に有効な薬剤が限定されることから、医学上の大きな問題になっている。
(「日和見感染」『フリー百科事典 ウィキペディア日本語版』 http://ja.wikipedia.org/) 更新日付:2020年7月6日01:29(UTC)現在での最新版より抜粋して引用。)
耐性化獲得試験【対象菌:MRSA】(抗菌機能)
細菌は投与された薬剤に対し、次第に対応してその薬剤が効きにくくなる性質がある。(菌の耐性化と呼ぶ)
MRSAに薬剤を添加したケースとリゾックスを添加したケースで、MRSAの耐性化レベルを比較したところ、リゾックスを添加したケースでは、MRSAは耐性をほぼ獲得できないという結果が得られた。
つまり他の薬剤と違い、リゾックスは投与する量を増やす事なく、有効性を維持できる事が判明した。


 東京医科歯科大学呼吸器内科 共同研究
東京医科歯科大学呼吸器内科 共同研究
PLoS ONE. 2019 May 28, 14(5): e0217504リゾックスはMRSAを耐性化させない
緑膿菌(注1)への抗菌効果
緑膿菌とは、免疫力が低下した時に緑膿菌感染症(注2)を引き起こす常在菌。
緑膿菌は様々な薬剤に対して耐性を獲得しているケースが多く、このような緑膿菌は多剤耐性緑膿菌と呼ばれ有効な薬剤が少ない為、医学上重要視されている。リゾックスはMRSA同様に緑膿菌に対して抗菌性を示す事が東京医科歯科大学呼吸器内科との共同研究で判明した。

東京医科歯科大学呼吸器内科 共同研究
東京医科歯科大学呼吸器内科 共同研究
PLoS ONE. 2019 May 28, 14(5): e0217504リゾックスは緑膿菌に対して抗菌効果を示す
(注1)緑膿菌とは
緑膿菌は、地球上の環境中に広く分布している代表的な常在菌の1つでもある。ヒトに対しても病原性を持つが、健常者に感染しても発病させることは無い。ただし免疫力の低下した者に感染すると、日和見感染症のうちの1つである緑膿菌感染症(※2)を起こす。 元々、緑膿菌は消毒薬や抗菌薬に対する抵抗性が高い上に、ヒトが抗菌薬を使用したことにより薬剤に対する耐性を獲得したものも多いため、緑膿菌感染症を発症すると治療が困難である。
(「緑膿菌」『フリー百科事典 ウィキペディア日本語版』 http://ja.wikipedia.org/) 更新日付:2020年4月19日00:55(UTC)現在での最新版より抜粋して引用。)(注2)緑膿菌感染症
緑膿菌感染症は、日和見感染症の1つで、医療用カテーテルや気管挿管、外科的手術などの医療行為によって尿道、気道、創傷からの感染を起こしたり、褥瘡や火傷、外傷などで皮膚のバリア機構が失われた部分から感染するケースが多い。このほか、コンタクトレンズ着脱時の損傷によって眼に感染を起こす場合も知られる。局所感染の場合は、眼では角膜炎や炎症、耳(外傷などによる)では「スイマーズイヤー (swimmer‘s ear、水泳者の耳)」とよばれる外耳炎、皮膚では化膿性発疹などを起こすほか、気道感染による肺炎を起こす場合もある。またこれらの局所感染に引き続き、あるいは創傷などからの血管内への感染によって全身感染を起こし、敗血症、続発性肺炎、心内膜炎、中枢神経感染などの重篤な疾患を引き起こすこともある。特に、緑膿菌敗血症では致死率は約80%に上ると言われている。
(「緑膿菌」『フリー百科事典 ウィキペディア日本語版』 http://ja.wikipedia.org/) 更新日付:2020年4月19日00:55(UTC)現在での最新版より抜粋して引用。)
電子顕微鏡による緑膿菌への抗菌効果の形態観察(抗菌機能)
リゾックスの緑膿菌に対する抗菌作用を観察した。
緑膿菌は通常は細長い棒状の形(桿菌)をしているが(写真左)、リゾックスを添加すると形状が大きく変化(球状化)し、正常な状態を維持する事が出来ない。(写真右)


 東京医科歯科大学共同研究
東京医科歯科大学共同研究
特定非営利活動法人総合画像研究支援
カンジダへの抗真菌(注1)効果
カンジダは健康な人でも、顔、手足、デリケートゾーン(性器部とその周辺部)などの身体の多くの部位に住み着いている常在菌。免疫力の低下などにより生育環境が変化すると、菌糸を伸ばし(写真左)、口腔カンジダ症や膣カンジダ症などの炎症を引き起こす。リゾックスはグラフ横軸の添加する濃度が高まるにつれ、カンジダの菌糸の形成を抑制する効果がある事が判明した。(写真右)


 帝京大学医真菌研究センター 共同研究
帝京大学医真菌研究センター 共同研究
Medical Mycology Journal. Vol.58 No.3, 2017リゾックスはカンジダの 菌糸形成を抑制する
(注1)真菌とは
真菌とはキノコ・カビ、単細胞性の酵母、鞭毛を持った遊走子などの多様な形態を示す真核生物であり、菌界に分類される生物群である。 外部の真菌あるいは常在する真菌類がヒトや脊椎動物の組織内に侵入し、異常に増殖すると真菌症を引き起こす。 代表的な真菌症として白癬菌による白癬(水虫、たむし、およびしらくも)やカンジダによるカンジダ症、クリプトコックスによるクリプトコックス症、アスペルギルスによるアスペルギルス症などが知られている。
「菌類」『フリー百科事典 ウィキペディア日本語版』 http://ja.wikipedia.org/) 更新日付:2020年2月17日15:23(UTC)現在での最新版より抜粋して引用。)
「真菌症」『フリー百科事典 ウィキペディア日本語版』 http://ja.wikipedia.org/) 更新日付:2020年7月9日04:09(UTC)現在での最新版より抜粋して引用。)
カンジダへの抗真菌効果映像






口腔カンジダ症モデルマウスによるリゾックスの効果(抗真菌機能)
口腔カンジダ症は、免疫力の低下やドライマウス(抗菌薬や降圧剤、抗精神薬等の服用よる唾液量の減少等)により発症する。口腔カンジダ症は舌全体にカンジダの厚い白苔の形成を示すが(写真左)、リゾックスを添加したケースでは白苔の形成が認められなかった(写真右)


 帝京大学医真菌研究センター 共同研究
帝京大学医真菌研究センター 共同研究
Medical Mycology Journal. Vol.58 No.3, 2017リゾックス塗布により口腔カンジダ症の
白苔の減少が見られた
抗炎症効果
炎症を引き起こす原因の1つに好中球の過剰活性が挙げられる。
好中球は血液中に存在し生体防御機能の一部を担当している白血球の一種で、病原体などの侵入で発生した炎症部に集まり活性化し、活性酸素や分解酵素を放出する事で我々の身体を守っている。
しかし好中球は、活性酸素や分解酵素などの過剰放出を起こすことがあり、体内の組織を破壊し、炎症をかえって進行させてしまう事がある。よって過剰な活性化と過剰放出を抑える事は、炎症を抑制する事につながる。活性化した好中球の粘着性が高くなる性質を利用し、その活性度を測定した結果、リゾックスを添加したケースでは、好中球が粘着性を持たず、粒の状態のままで存在している事から、過剰な活性化をしていない事が判明した。(写真右)


 帝京大学医真菌研究センター 共同研究
帝京大学医真菌研究センター 共同研究
獣医臨床皮膚科 25(3):133-141,2019リゾックスによる抗炎症作用が示唆された
悪臭物質への消臭試験結果

リゾックスは各種悪臭物質に対し、消臭効果を示す。
測定試験は外部の評価機関にて実施した。
リゾックスは各種悪臭物質に対し、消臭効果を示す。
測定試験は外部の評価機関にて実施した。
■アセトアルデヒド■イソ草吉酸■ノネナール体臭やタバコの煙に含まれる物質足の臭いに含まれる物質加齢臭に含まれる物質初期ガス濃度:約20ppm
試験方法 :10分後の濃度を測定初期ガス濃度:約20ppm
試験方法 :10分後の濃度を測定初期ガス濃度:約17ppm
試験方法 :30分後の濃度を測定試験区分臭気濃度
(PPM)減少率
(%)試験区分臭気濃度
(PPM)減少率
(%)試験区分臭気濃度
(PPM)減少率
(%)リゾックス1240%リゾックス1.0未満95%以上リゾックス759%対照
(無添加)20-対照
(無添加)20-対照
(無添加)16-
■アンモニア■トリメチルアミン尿、汗、呼気に含まれる物質腐敗臭に含まれる物質初期ガス濃度:約100ppm
試験方法 :10分後の濃度を測定初期ガス濃度:約70ppm
試験方法 :10分後の濃度を測定試験区分臭気濃度
(PPM)減少率
(%)試験区分臭気濃度
(PPM)減少率
(%)リゾックス1.0未満99%以上リゾックス1.0未満99%以上対照
(無添加)100-対照
(無添加)70-■アセトアルデヒド■イソ草吉酸■ノネナール体臭やタバコの煙に含まれる物質足の臭いに含まれる物質加齢臭に含まれる物質初期ガス濃度:約20ppm
試験方法 :10分後の濃度を測定初期ガス濃度:約20ppm
試験方法 :10分後の濃度を測定初期ガス濃度:約17ppm
試験方法 :30分後の濃度を測定試験区分臭気濃度
(PPM)減少率
(%)試験区分臭気濃度
(PPM)減少率
(%)試験区分臭気濃度
(PPM)減少率
(%)リゾックス1240%リゾックス1.0未満95%以上リゾックス759%対照
(無添加)20-対照
(無添加)20-対照
(無添加)16-■アンモニア■トリメチルアミン尿、汗、呼気に含まれる物質腐敗臭に含まれる物質初期ガス濃度:約100ppm
試験方法 :10分後の濃度を測定初期ガス濃度:約70ppm
試験方法 :10分後の濃度を測定試験区分臭気濃度
(PPM)減少率
(%)試験区分臭気濃度
(PPM)減少率
(%)リゾックス1.0未満99%以上リゾックス1.0未満99%以上対照
(無添加)100-対照
(無添加)70-■アセトアルデヒド体臭やタバコの煙に含まれる物質初期ガス濃度:約20ppm
試験方法 :10分後の濃度を測定試験区分臭気濃度
(PPM)減少率
(%)リゾックス1240%対照
(無添加)20-■イソ草吉酸足の臭いに含まれる物質初期ガス濃度:約20ppm
試験方法 :10分後の濃度を測定試験区分臭気濃度
(PPM)減少率
(%)リゾックス1.0未満95%以上対照
(無添加)20-■ノネナール加齢臭に含まれる物質初期ガス濃度:約17ppm
試験方法 :30分後の濃度を測定試験区分臭気濃度
(PPM)減少率
(%)リゾックス759%対照
(無添加)16-■アンモニア尿、汗、呼気に含まれる物質初期ガス濃度:約100ppm
試験方法 :10分後の濃度を測定試験区分臭気濃度
(PPM)減少率
(%)リゾックス1.0未満99%以上対照
(無添加)100-■トリメチルアミン腐敗臭に含まれる物質初期ガス濃度:約70ppm
試験方法 :10分後の濃度を測定試験区分臭気濃度
(PPM)減少率
(%)リゾックス1.0未満99%以上対照
(無添加)70-
安全性試験実施状況
■LYZOXの安全性試験結果



-
様々な菌へのリゾックスの抗菌データ





